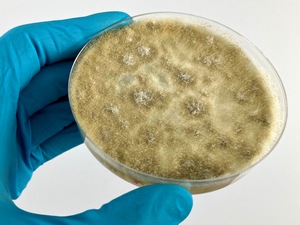

Antibakterielle Materialprüfungen

Die Auswahl des idealen Prüfverfahrens von antimikrobiellen Eigenschaften ist von vielen Faktoren abhängig, z.B. Materialeigenschaften, Saugfähigkeit, Wassergehalt, Hydophilie, Hydrophobizität, Oberflächenstrukturierung, Prototypen-/Produktgröße, etc.
Darüber hinaus ist die Wahl von geeigneten Testorganismen, die neben den Standard-Prüforganismen in den Anwendungsbereichen anzutreffen sind, von Bedeutung. Unser Labor besitzt daher eine große Stammsammlung an Prüforganismen, inklusive vieler resistenter und multiresistenter Varianten, z.B. MRSA, MRSE, VRE, ESBL, MRGN-Stämme.
Wir beraten Sie gerne bei der Auswahl der geeignesten Prüfverfahren für Ihr Produkt in Ihrer Anwendung.
ISO 22196: Measurement of antibacterial activity on plastics and other non-porous surfaces
JIS Z 2801: Antibacterial products – Test for antibacterial activity and efficacy
ASTM E 2180: Standard Test Method for Determining the Activity of Incorporated Antimicrobial Agent(s) In Polymeric or Hydrophobic Materials
ASTM E 2149: Standard Test Method for Determining the Antimicrobial Activity of Antimicrobial Agents Under Dynamic Contact Conditions
ASTM E 2315: Assessment of Antimicrobial Activity Using a Time-Kill Procedure
ISO 20743: Textiles – Determination of antibacterial activity of textile products
AATCC 100: Antibacterial Finishes on Textile Materials: Assessment of
ISO 7581: Evaluation of bactericidal activity of a non-porous antimicrobial surface used in a dry environment
DIN 58940-3: Susceptibility testing of microbial pathogens to antimicrobial agents – Part 3: Agar diffusion test
DIN EN ISO 11737: Part 2: Tests of sterility performed in the definition, validation and maintenance of a sterilization process
DIN EN 16615: Chemical disinfectants and antiseptics – Quantitative test method for the evaluation of bactericidal and yeasticidal activity on non-porous surfaces with mechanical action employing wipes in the medical area (4-field test) – (phase 2, step 2)
Proliferation Assay: Proliferation-based assay for the determination of antimicrobial surface properties
Mixed-Culture Assay: Differential analysis of bacterial adhesion, proliferation and antimicrobial efficacy of material surfaces against mixed cultures of bacteria
DIN EN 1276: Chemical disinfectants and antiseptics –Quantitative suspension test for the evaluation of bactericidal activity of chemical disinfectants and antiseptics used in food, industrial, domestic and institutional areas
DIN EN 1650: Chemical disinfectants and antiseptics – Quantitative suspension test for the evaluation of fungicidal or yeasticidal activity of chemical disinfectants and antiseptics used in food, industrial, domestic and institutional areas
DIN EN 13727: Chemical disinfectants and antiseptics – Quantitative suspension test for the evaluation of bactericidal activity in the medical area – Test method and requirements (phase 2, step 1)
Pilztests
Die Pilztests untersuchen die Widerstandsfähigkeit von Materialien gegenüber verschiedener Pilze oder Pilzgemische. Auch hier spielen Materialeigenschaften wie chemische Zusammensetzung, Saugfähigkeit, Wassergehalt, Hydophilie, Hydrophobizität, Oberflächenstrukturierung oder Prototypen-/Produktgröße eine wichtige Rolle.
Wir beraten Sie gerne bei der Auswahl der geeignesten Prüfverfahren für Ihr Produkt in Ihrer Anwendung.
DIN EN ISO 846: Plastics – Evaluation of the action of microorganisms (Method A and B)
ASTM G 21: Standard Practice for Determining Resistance of Synthetic Polymeric Materials to Fungi
BS 3900 G6: Assessment of resistance to fungal growth
ISO 13629-2: Textiles – Determination of antifungal activity of textile products – Part 2: Plate count method
DIN EN 15457: Paints and varnishes – Laboratory method for testing the efficacy of film preservatives in a coating against fungi
Dichtigkeitsuntersuchungen von Medizinprodukten
Die Dichtigkeit von Medizinprodukten gewährleistet, dass sowohl chemische Komponenten nicht aus den Systemen nach außen dringen können als auch keine mikrobielle Verkeimung während des Gebrauchs in die Systeme eindringen können. Dies ist insbesondere für Medizinprodukte, die direkten Zugang zu Patienten haben und manuelle Eingriffe in der Benutzung beinhalten, ein kritischer Aspekt.
Neben Standardmethoden hat das Labor speziell für diese Anforderungen Testverfahren entwickelt.
Wir beraten Sie gerne bei der Auswahl der geeignesten Prüfverfahren für Ihr Produkt in Ihrer Anwendung.

DIN EN ISO 24072: Aerosol bacterial retention test method for air-inlet on administration devices
YY/T 1551.1: Air filters for medical infusion and transfusion equipment – Part 1: Aerosol bacterial retention test method
Aerosol Contamination Test: Microbial Barrier Testing by means of Bacterial Aerosol Contamination
Touch Contamination Test: Microbial Barrier Testing by means of Bacterial Touch Contamination
Chemical Tightness Test: Closed System Test by means of a fluorescent tracer
DIN 58953-6: Sterilisation – Sterilgutversorgung – Teil 6: Prüfung der Keimdichtigkeit von Verpackungsmaterialien für zu sterilisierende Medizinprodukte